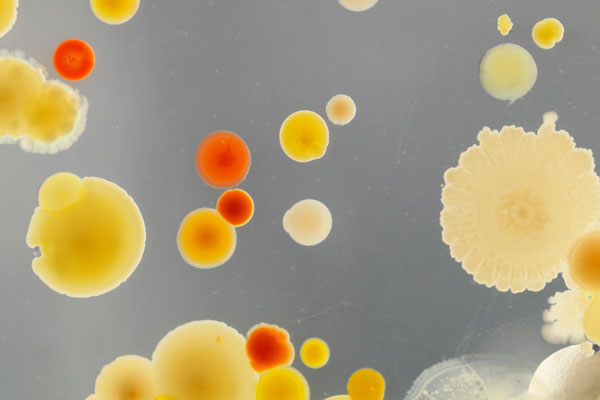

Narcissisme
Spieglein, Spieglein
Es gibt Narziss, den Protagonisten aus dem gleichnamigen Mythos, und es gibt den Narzissmus. Dazwischen gibt es: mehrere Jahrhunderte und unzählige Auslegungen. Und, so könnte man meinen, es gibt immer mehr Narzisst_innen. Bleibt die Frage, ob der Narzissmus je länger je mehr die Gesellschaft prägt – oder ob nicht vielleicht wir den Begriff immer neu erfinden und anpassen.
Dossier
Narcissisme
Spieglein, Spieglein
Edito
A l’heure où nous mettons sous presse, la situation – étrange et effrayante – semble avoir renversé les paradigmes. De notre dossier